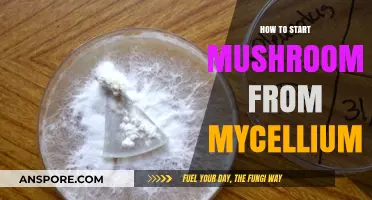
Growing Mushrooms from Mycelium: A Beginner's Guide to Cultivation

Steaming mushrooms on the stove is a simple and effective method to retain their natural flavor, texture, and nutrients. This technique involves using a steamer basket or a makeshift setup with a pot and lid to gently cook the mushrooms with steam. It’s a healthier alternative to sautéing or frying, as it requires no oil, and it’s perfect for preparing mushrooms as a side dish, salad topping, or ingredient in various recipes. With just a few basic tools and minimal effort, you can achieve tender, flavorful mushrooms that complement any meal.
| Characteristics | Values |
|---|---|
| Method | Steaming on stove |
| Equipment Needed | Pot with lid, steamer basket or colander |
| Water Requirement | 1-2 inches of water in the pot |
| Preparation Time | 5 minutes |
| Cooking Time | 5-7 minutes |
| Mushroom Types | Button, cremini, shiitake, or any firm mushroom variety |
| Cleaning Mushrooms | Gently wipe with a damp cloth or brush; avoid soaking |
| Seasoning (Optional) | Salt, pepper, garlic, herbs (added after steaming) |
| Heat Level | Medium-high to bring water to a boil, then reduce to medium |
| Steaming Time | 5-7 minutes until tender but not mushy |
| Checking Doneness | Mushrooms should be soft and slightly shrunk |
| Serving Suggestions | As a side dish, in salads, or added to stir-fries |
| Nutritional Benefits | Low in calories, high in vitamins (e.g., D, B), and antioxidants |
| Storage (Cooked) | Refrigerate in an airtight container for up to 3 days |
| Reheating | Gently reheat in a pan or microwave |
| Notes | Avoid overcrowding the steamer basket for even cooking |
Explore related products
What You'll Learn
- Prepare mushrooms: Clean, trim stems, and slice evenly for consistent steaming
- Choose pot: Use a wide pot with a tight-fitting lid for steaming
- Add water: Pour 1 inch of water into the pot, bring to a boil
- Steam setup: Place mushrooms in a steamer basket above the water
- Cooking time: Steam for 5-7 minutes until tender, then serve immediately

Prepare mushrooms: Clean, trim stems, and slice evenly for consistent steaming
Preparing mushrooms for steaming begins with cleaning them properly. Mushrooms are delicate and absorb water easily, so avoid submerging them in water. Instead, use a damp paper towel or a soft brush to gently wipe away any dirt or debris from the surface. If necessary, briefly rinse them under cold running water, ensuring you pat them dry immediately with a clean kitchen towel. This step is crucial to prevent the mushrooms from becoming waterlogged, which can affect their texture during steaming.
Once cleaned, the next step is to trim the stems. Hold each mushroom firmly by the cap and twist the stem to remove it. For larger mushrooms, trim the tough, woody end of the stem using a small knife. If you’re using smaller mushrooms like button or cremini, simply snapping off the stem at the base is often sufficient. Trimming ensures that the mushrooms cook evenly and prevents any bitter flavors from the stem bases.
After trimming, slice the mushrooms evenly to promote consistent steaming. Aim for slices that are about ¼ to ½ inch thick, depending on the size of the mushrooms. Even slicing ensures that all pieces cook at the same rate, avoiding overcooked or undercooked sections. For smaller mushrooms, you can leave them whole or halve them if desired. Uniformity in size and shape is key to achieving perfectly steamed mushrooms.
Before steaming, arrange the prepared mushrooms in a single layer in a steamer basket or on a heat-safe plate that fits inside your steaming setup. Overcrowding can lead to uneven cooking, so ensure there’s enough space for steam to circulate around each piece. If you don’t have a steamer basket, you can improvise by using a metal colander or a heat-safe plate elevated above the water in a pot.
Finally, ensure your steaming setup is ready by adding water to a pot and bringing it to a simmer. The water level should be low enough that it doesn’t touch the bottom of the steamer basket or plate. Once the water is simmering, place the mushrooms in the steamer, cover the pot, and let them steam for 3 to 5 minutes, depending on their thickness. Properly prepared mushrooms will emerge tender, evenly cooked, and ready to be enjoyed.
Mushrooms' Magic: Unveiling Their Surprising Skin Benefits and Uses
You may want to see also

Choose pot: Use a wide pot with a tight-fitting lid for steaming
When steaming mushrooms on the stove, selecting the right pot is crucial for achieving the best results. The ideal pot for this task is one that is wide and comes with a tight-fitting lid. A wide pot allows the mushrooms to be spread out in a single layer, ensuring even steaming and preventing them from becoming soggy or overcrowded. This arrangement also promotes better heat distribution, as the steam can circulate freely around each mushroom. A tight-fitting lid is equally important because it traps the steam inside, creating a consistent and efficient cooking environment. Without a proper seal, steam escapes, prolonging the cooking time and potentially drying out the mushrooms.
The material of the pot is another factor to consider. Stainless steel or glass pots are excellent choices because they heat evenly and retain heat well. Avoid using pots with non-stick coatings, as high heat and steam can degrade the coating over time. Additionally, a pot with a heavy bottom is preferable, as it helps maintain a steady temperature and reduces the risk of hot spots that could unevenly cook the mushrooms. If you have a dedicated steamer insert, it can be placed inside the wide pot to elevate the mushrooms above the water, but this is not strictly necessary if you’re steaming for a short period.
The size of the pot should also be appropriate for the quantity of mushrooms you’re steaming. While a wide pot is ideal, it shouldn’t be so large that the mushrooms are spread too far apart, as this can lead to uneven cooking. Aim for a pot that allows the mushrooms to fit comfortably in a single layer with a bit of space around each one. If you’re steaming a large batch, consider using multiple pots or steaming in batches to maintain the quality of the mushrooms.
Another important aspect is the lid’s tightness. A lid that fits snugly prevents steam from escaping, ensuring that the mushrooms cook quickly and retain their moisture. If your pot’s lid doesn’t fit perfectly, you can place a layer of aluminum foil over the pot before adding the lid to create a better seal. This makeshift solution can be particularly useful if you’re working with an older or mismatched pot and lid.
Lastly, consider the ease of handling the pot. A wide pot with a tight-fitting lid should also have sturdy handles for safe and comfortable maneuvering. Since steaming involves boiling water and hot steam, it’s essential to use a pot that you can lift and move without difficulty. This ensures not only the quality of the steamed mushrooms but also your safety during the cooking process. By choosing the right pot, you set the foundation for perfectly steamed mushrooms that are tender, flavorful, and ready to be enjoyed.
Mushroom Glowing: Is It Safe or Not?
You may want to see also

Add water: Pour 1 inch of water into the pot, bring to a boil
To begin steaming mushrooms on the stove, the first crucial step is to add water to your pot. Start by selecting a pot that is appropriately sized for the amount of mushrooms you plan to steam. A medium-sized pot with a lid works well for most batches. Pour 1 inch of water into the bottom of the pot, ensuring it’s enough to generate steam but not so much that it risks boiling over or diluting the mushroom flavor. The water level should be consistent across the pot’s base, creating an even foundation for steaming. This shallow layer of water is key, as it will heat up quickly and produce the steam needed to cook the mushrooms gently.
Once the water is in the pot, place it on the stove over medium-high heat. Turn the burner on and allow the water to heat gradually. As the water warms up, it will begin to release steam, which is essential for the steaming process. Keep an eye on the pot as the water approaches a boil. You’ll notice small bubbles forming at the bottom, and the steam will become more visible. This is a sign that the water is nearing the desired temperature, but it’s important to wait until it reaches a full boil before proceeding to the next step.
Bringing the water to a boil is critical because it ensures that the steam is hot enough to cook the mushrooms efficiently. A gentle boil is ideal—you should see steady bubbles rising to the surface, but the water shouldn’t be violently bubbling or splashing. If the water is boiling too aggressively, you can slightly reduce the heat to maintain a steady simmer. The goal is to create a consistent steam environment that will cook the mushrooms evenly without overcooking them or causing them to become soggy.
While waiting for the water to boil, you can prepare the mushrooms by cleaning them and placing them in a steamer basket or a heat-safe plate that fits inside the pot. Ensure the mushrooms are dry to prevent excess moisture from affecting the steaming process. Once the water is at a full boil, you’re ready to add the mushrooms and begin steaming. The boiling water will immediately generate steam, which will rise and envelop the mushrooms, cooking them gently and preserving their texture and flavor.
Finally, remember that the amount of water you add is important—1 inch is the recommended depth to ensure sufficient steam production without wasting energy or risking overflow. Too little water may cause the pot to burn or run dry before the mushrooms are cooked, while too much water can slow down the boiling process and dilute the steam’s effectiveness. By carefully measuring and monitoring the water level, you’ll set the stage for perfectly steamed mushrooms that are tender, flavorful, and ready to be enjoyed.
Turkey Tail Mushrooms: A Psychedelic Journey?
You may want to see also
Explore related products

Steam setup: Place mushrooms in a steamer basket above the water
Steaming mushrooms on the stove is a simple and effective method to retain their delicate flavor and texture. The key to success lies in the proper setup, ensuring the mushrooms are steamed evenly without becoming waterlogged. Steam setup: Place mushrooms in a steamer basket above the water is the foundational step in this process. Begin by selecting a pot with a tight-fitting lid, as this will help trap the steam and cook the mushrooms efficiently. Fill the pot with a small amount of water, typically around 1 to 2 inches, ensuring it does not touch the bottom of the steamer basket when placed inside. The water should be just enough to generate steam but not so much that it risks boiling over or splashing onto the mushrooms.
Next, prepare the steamer basket by ensuring it fits securely inside the pot. If you don’t have a traditional steamer basket, you can improvise with a heat-safe plate or a makeshift rack, as long as it keeps the mushrooms elevated above the water. The goal is to create a barrier that allows steam to circulate around the mushrooms without submerging them. Once the basket is in place, arrange the mushrooms in a single layer, avoiding overcrowding. Overcrowding can prevent even steaming, so if you have a large batch, consider steaming in multiple rounds or using a larger pot with a wider steamer basket.
Before placing the mushrooms in the basket, give them a quick rinse under cold water to remove any dirt or debris. Pat them dry gently with a paper towel or clean cloth, as excess moisture can affect the steaming process. If the mushrooms are particularly large, such as portobellos, slice them into halves or quarters to ensure they cook evenly. Smaller varieties like button or cremini mushrooms can be left whole. Once the mushrooms are prepared, place them carefully into the steamer basket, ensuring they are spread out for maximum exposure to the steam.
With the mushrooms in the basket, place the pot on the stove and turn the heat to medium-high. Allow the water to come to a steady simmer, which will generate the steam needed to cook the mushrooms. Once the water is simmering, cover the pot with the lid to trap the steam inside. The cooking time will vary depending on the size and type of mushrooms, but generally, it takes about 5 to 7 minutes for them to become tender and slightly softened. Avoid lifting the lid too often, as this releases the steam and can prolong the cooking time.
Finally, once the mushrooms are steamed to your desired tenderness, carefully remove the steamer basket from the pot using oven mitts or tongs, as both the basket and the steam will be hot. Transfer the steamed mushrooms to a serving dish or use them immediately in your recipe. Steaming mushrooms on the stove using a steamer basket above the water is a quick, healthy, and flavorful way to prepare them, making it an excellent technique for various culinary applications.
White Mushrooms and Carb Content: What You Need to Know
You may want to see also

Cooking time: Steam for 5-7 minutes until tender, then serve immediately
Steaming mushrooms on the stove is a quick and effective method to retain their delicate flavor and texture. To begin, Cooking time: Steam for 5-7 minutes until tender, then serve immediately, you’ll need a pot with a tight-fitting lid and a steamer basket or a makeshift setup using a heat-safe plate or bowl. Fill the pot with about an inch of water, ensuring it doesn’t touch the bottom of the steamer basket. Bring the water to a steady simmer over medium heat. While the water heats up, prepare your mushrooms by gently wiping them clean with a damp cloth or paper towel to remove any dirt. Avoid washing them under running water, as mushrooms absorb moisture easily, which can affect their texture during cooking.
Once the water is simmering, place the mushrooms in the steamer basket or on your makeshift setup. Cooking time: Steam for 5-7 minutes until tender, then serve immediately is crucial here, as overcooking can make the mushrooms soggy. Cover the pot with the lid to trap the steam, which will cook the mushrooms evenly. Set a timer to ensure you don’t exceed the recommended cooking time. The steam will gently cook the mushrooms, making them tender while preserving their natural juices and nutrients.
During the steaming process, resist the urge to lift the lid frequently, as this releases the steam and extends the cooking time. After Cooking time: Steam for 5-7 minutes until tender, then serve immediately, carefully remove the lid, tilting it away from you to avoid steam burns. Check the mushrooms for doneness by inserting a fork or knife into one of them—it should slide in easily if they are tender. If they still feel firm, steam for an additional minute or two, but keep a close eye to prevent overcooking.
Once the mushrooms are tender, remove the steamer basket or plate from the pot using oven mitts or tongs, as it will be hot. Transfer the steamed mushrooms to a serving dish immediately to stop the cooking process. Steamed mushrooms are best served right away to enjoy their optimal texture and flavor. You can season them simply with a drizzle of olive oil, a sprinkle of salt, pepper, and fresh herbs like parsley or thyme for added freshness.
In summary, Cooking time: Steam for 5-7 minutes until tender, then serve immediately is the key to perfectly steamed mushrooms. This method ensures they remain tender, flavorful, and ready to complement any dish. Whether you’re using them as a side, adding them to salads, or incorporating them into main courses, steaming on the stove is a straightforward and efficient technique that delivers excellent results every time.
Psychedelic Mushrooms: Do They Show on Drug Tests?
You may want to see also
Frequently asked questions
You’ll need a pot with a lid, a steamer basket or a heat-safe plate that fits inside the pot, and water.
Steaming mushrooms typically takes 3–5 minutes once the water is boiling, depending on the size of the mushrooms.
Yes, you can add herbs, garlic, or a pinch of salt directly to the steamer basket or sprinkle them on the mushrooms after steaming for added flavor.